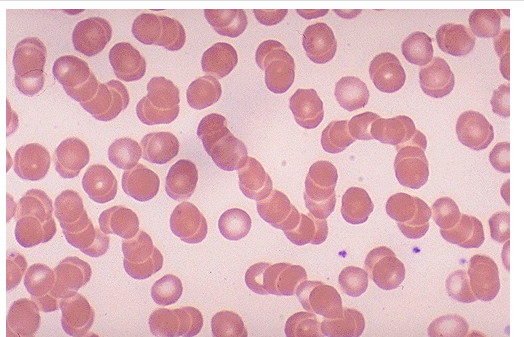
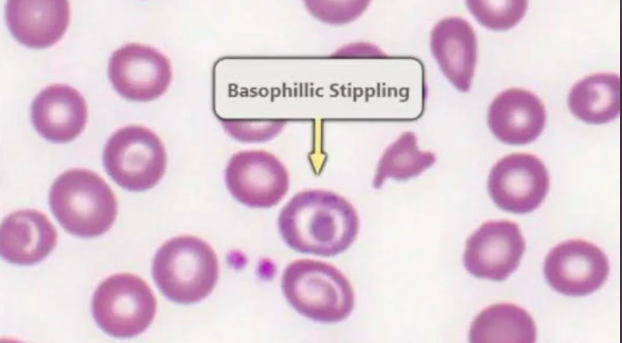

Which indications would cause you to refer immediately for specialist referral suspecting leukaemia, in children up to 25yrs []
- Unexplained petachiae
- Hepatosplenomegaly
- Unexplained bleeding / bruising
- Pallor
- Unexplained fever
- Unexplained persistent infections
- Generalised lymphadenopathy
Most common causes of massive splenomegaly in UK? [2]
Most common causes of massive splenomegaly in UK = CML/myelofibrosis
Which patient population is at increased risk of acute lymphoid leukaemia? [1]
Downs syndrome
What would you do if a patient has a 2-level Wells score < 1 and suspect DVT / PE? [1]
Arrange D-dimer and prescribe anticoagulation if wait for results is greater than 4 hrs
What are the 4 stages for HL staging for Ann-Arbor staging? [4]
Stage I
- Single LN
Stage II
- 2+ LN on same side of diaphragm
Stage III:
- LNs on both sides of diaphragm
Stage IV:
- Spread beyond LN
A: No systemic symptoms other than pruiritis
B: Weight loss (> 10 %); fever >38; night sweats)
Which B symptom indicates a poor prognosis for HL? [1]
night sweats
What is the MoA of rivaroxaban? [1]
Direct factor Xa inhibitor
What is the empirical antibiotic of choice for neutropenic sepsis? [2]
IV Piperacillin with tazobactam
What is a common complication of cancer therapy (particularly chemo)? [1]
Neutropenic sepsis
What neutrophil levels indicate neutropenic sepsis? [1]
What other signs do you need? [2]
< 0.5
AND one of:
- Temp > 38
- Other signs or symptoms of significant sepsis
How do you reverse minor allergic reactions in blood transfusions? [2]
Urticaria and pruritus without evidence of haemodynamic instability
Stop transfusion;
Give an antihistamine
Which electrolyte changes indicate tumour lysis syndrome? [4]
What else do you need for a diagnosis? [3]
Electrolyte changes:
* Uric acid > 475 or 25% increase
* K > 6 or 25% increase
* Phosphate > 1.125 or 25% increase
* Calcium < 1.75 or 25% increase
Positive clinical TLS signs:
- Increased serum creatitine (1.5x upper limit of normal)
- Cardiac arrythmia / sudden death
- Seizure
What is the diagnositic investigation of choice for suspected NHL? [1]
Excisional node biopsy
How do you remember the most important symptoms / complications of myeloma? [6]
CRABBI:
- Calcium raised
- Renal failure
- Anaemia
- Bone pain
- Bleeding
- Infection
Describe what is meant by a rouleaux formation [1]
The RBC’s here have stacked together in long chains.
Name this haemological abnormalilty [1]

rouleaux formation: the RBC’s here have stacked together in long chains.
Which pathology does a rouleaux formation indicate? [1]
Myeloma
A patient undergoes a biopsy of a mass in their ceceum. It exhbitis a ‘starry sky’ pattern. What is the most likely infection? [1]
EBV: causes Burkitt’s lymphoma
Which lymph nodes does Burkitt’s lymphoma typically present in? [1]
Abdomen and mesenteric lymph nodes
Burkitt’s lymphoma typically causes what complication? [1]
Tumour lysis syndrome
Basophilic stippling of red blood cells indicates which form of anaemia? [1]
Sideroblastic anaemia (where RBC fail to form haem: leads to deposits of Fe in the mitochondira that forms a ring around the nucleus called a ring sideroblast)
DVT investigation: if the scan is negative, but the D-dimer is positive what is the next appropriate steps in patient management? [2]
stop anticoagulation and repeat scan in 1 week
What is the mechanism of action of dabigatran?
Direct thrombin inhibitor
Protein C inhibitor
Direct factor Xa inhibitor
Direct antithrombin III inhibitor
Factor II, VII, IX and X inhibitor
What is the mechanism of action of dabigatran?
Direct thrombin inhibitor
Protein C inhibitor
Direct factor Xa inhibitor
Direct antithrombin III inhibitor
Factor II, VII, IX and X inhibitor
What blood film results would indicate chronic leukocytic leukaemia (CLL)? [2]
Smear cells
small/medium-sized lymphocytes





































